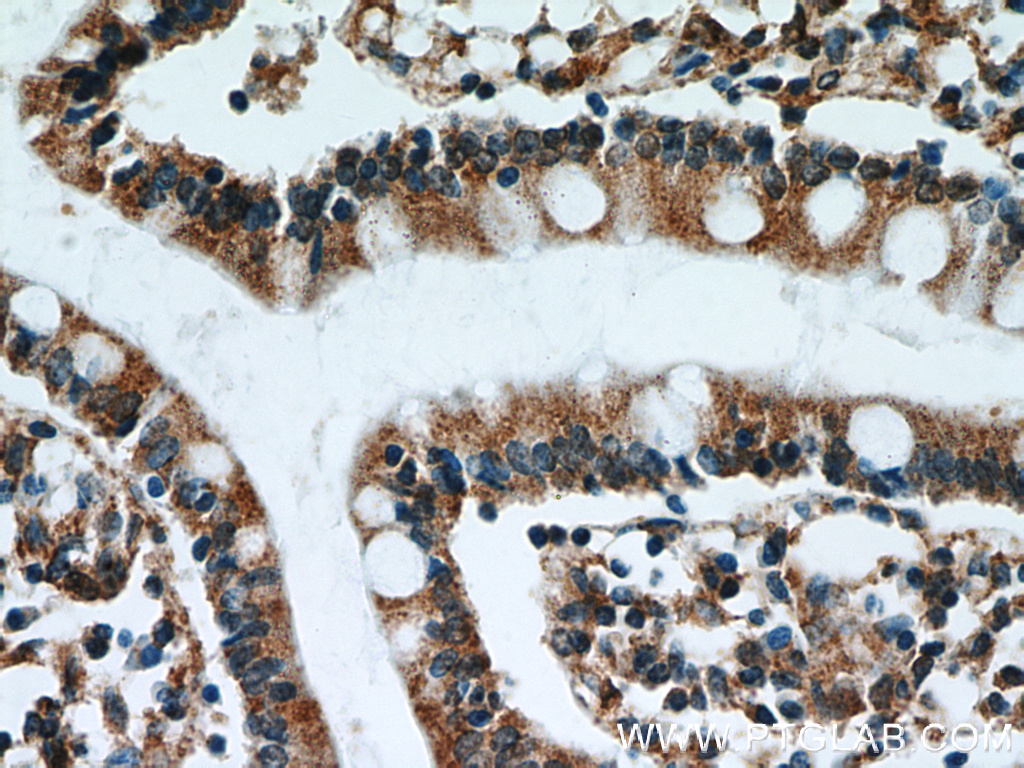
ATF4 Antibody 600351Ig Proteintech

L'ATF4 (pour « Activating transcription factor 4 ») est un facteur de transcription de la famille des ATF dont le gène est ATF4 situé sur le chromosome 22 humain.
Rôles
L'ATF4 intervient pour la transcription de plusieurs gènes jouant sur le métabolisme cellulaire. Son activité favorise la prolifération tumorale ainsi que la résistance aux traitements anticancéreux comme pour le cisplatine.
Il intervient également dans l'embryogenèse.
Au cours d'un stress, en particulier de nature hypoxique, son activité est fortement diminuée.
Notes et références
- Portail de la médecine
- Portail de la biologie cellulaire et moléculaire